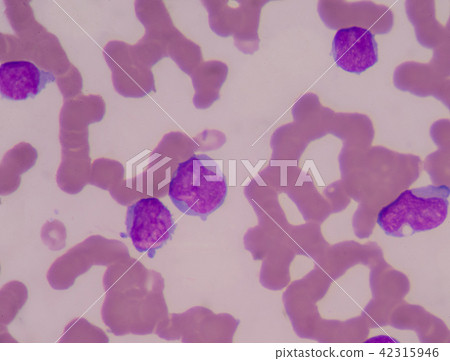

azeri immature

π£ ππ»ππ»ππ» FOR MORE INFORMATION, CLICK HERE ππ»ππ»ππ»
Yu Gi Oh Nude Videos - Amy Sex
Vaginal Dildo
Yangicha Sex Hikoyalar
Bangbros Cuban
She drives solo again.
Bangmystepmom Model Family Mature Sexy Porn Pics 2
Butter Face Anal Wench Shy Love
azeri immature

g_north_west">h_954">w_954/co_000000">e_outline:35/co_000000">e_outline:inner_fill:35/co_ffffff">e_outline:35/co_ffffff">e_outline:inner_fill:35/co_bbbbbb">e_outline:3:1000/c_mpad">g_center">h_1260">w_1260/b_rgb:eeeeee/t_watermark_lock/c_limit">f_auto">h_630">q_90">w_630/v1610807394/production/designs/18557201_0.jpg">






























